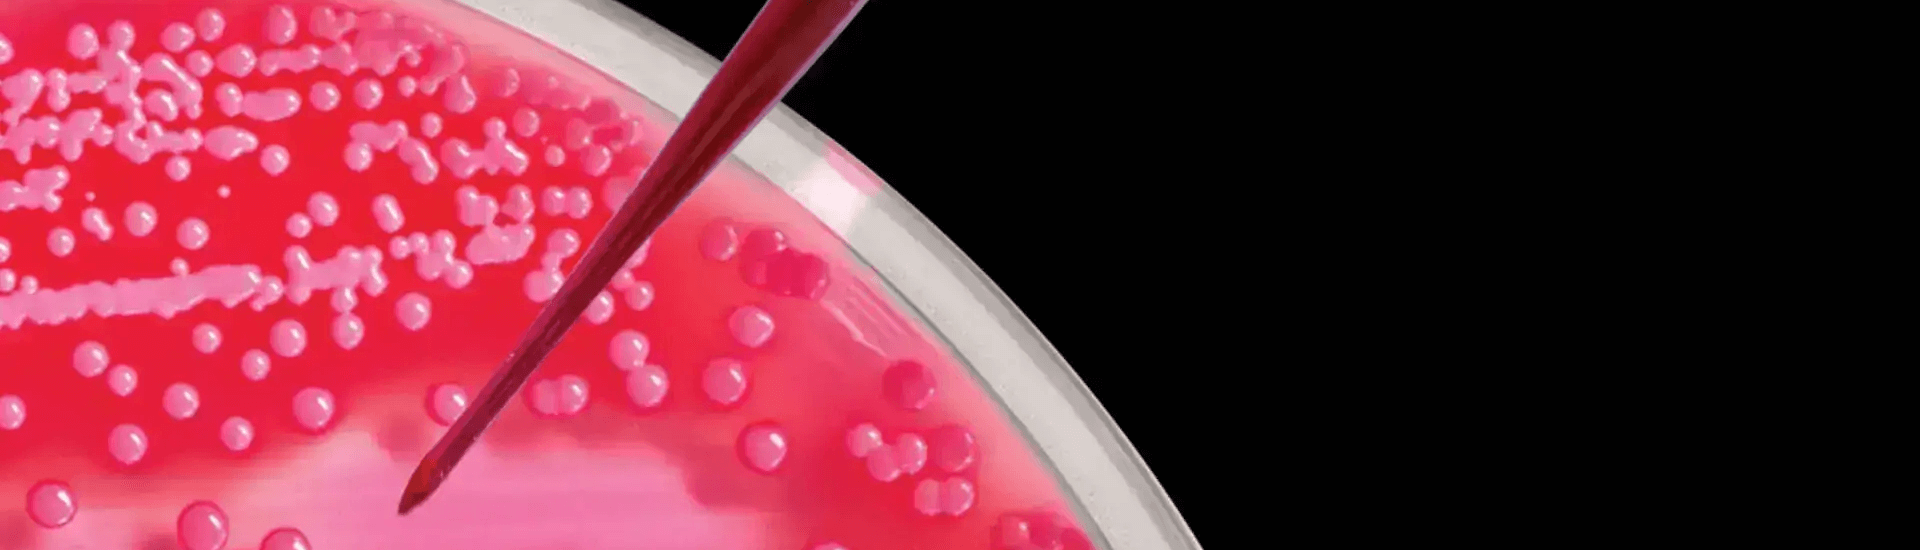

MICROBIOLOGY
At InfeXn, the diagnostic systems include automated continuous monitoring blood culture systems, automated microbial identification and antimicrobial susceptibility testing systems with the MIC value of the antibiotics that make us one of the few laboratories in the entire country with fully automated systems. We have world class instruments that enable drug sensitivity testing for a wide range of antimicrobial and antifungal drugs, enabling physicians to choose from a range of antibiotics according to MIC values.